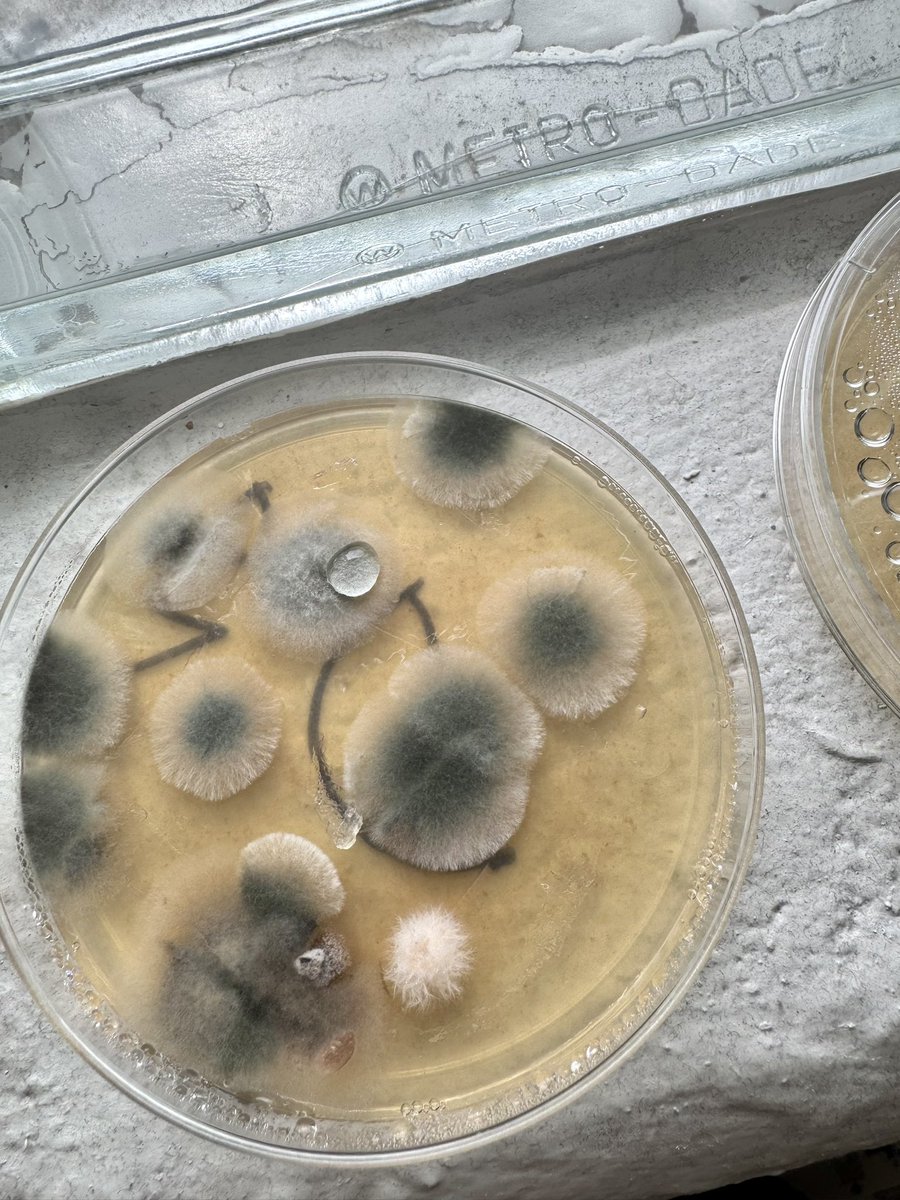
Ms. Williams tweet media

8th Grade is working extra hard on Science Mastery and it shows! The "M&M" Party was a huge success. Congratulations to our students who scored Meets or Masters on Checkpoint 1 🤩 @HumbleISD_TMS




English
Ms. Williams
629 posts

@dubsdoesscience
Science Instructional Coach and STEM Academy Coordinator at Timberwood MS 👩🏼🔬 UH Alumna 🐾 Go Coogs! Momma to 👦🏻👧🏻 • 🐱
























I had a Great Week at Junior Olympics taking 5th place in the 1500 with a time of 4:04 and 8th in the 4x8 with a 1:58 Split‼️And becoming a Junior Olympic champion in the 3k I am officially a 4X All American 🇺🇸.#ALLGLORYTOGOD #TheUnattached #Juniorolympics